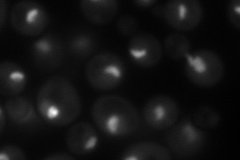
YDR398W
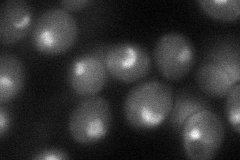
YDR398W
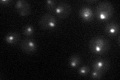
YDR398W

View description
Subunit of U3-containing Small Subunit (SSU) processome complex involved in production of 18S rRNA and assembly of small ribosomal subunit
Localization:
Intensity:
Fold change:
Significance:
-
C’ GFP library in SD

nucleolus92.94 -
N' NOP1pr-GFP in SD
nucleolus90.4254 -
N' TEF2pr-mCherry in SD

nucleolus29.4922 -
N' NATIVEpr-GFP in SD

nucleolus46.7562 -
N' TEF2pr-VC and Cyto-VN in SD
nucleolus50.4025 -
C’ GFP library in SD+DTT

nucleolus69.910.75No -
C’ GFP library in SD+H2O2

nucleolus92.640.99No -
C’ GFP library in Starvation Media
nucleolus45.320.48Yes -
C’ GFP library on the background of Pup2-DaMP

nucleolus -
C’ GFP library on the background of CCT mutant

nucleolus97.13851.04513No
